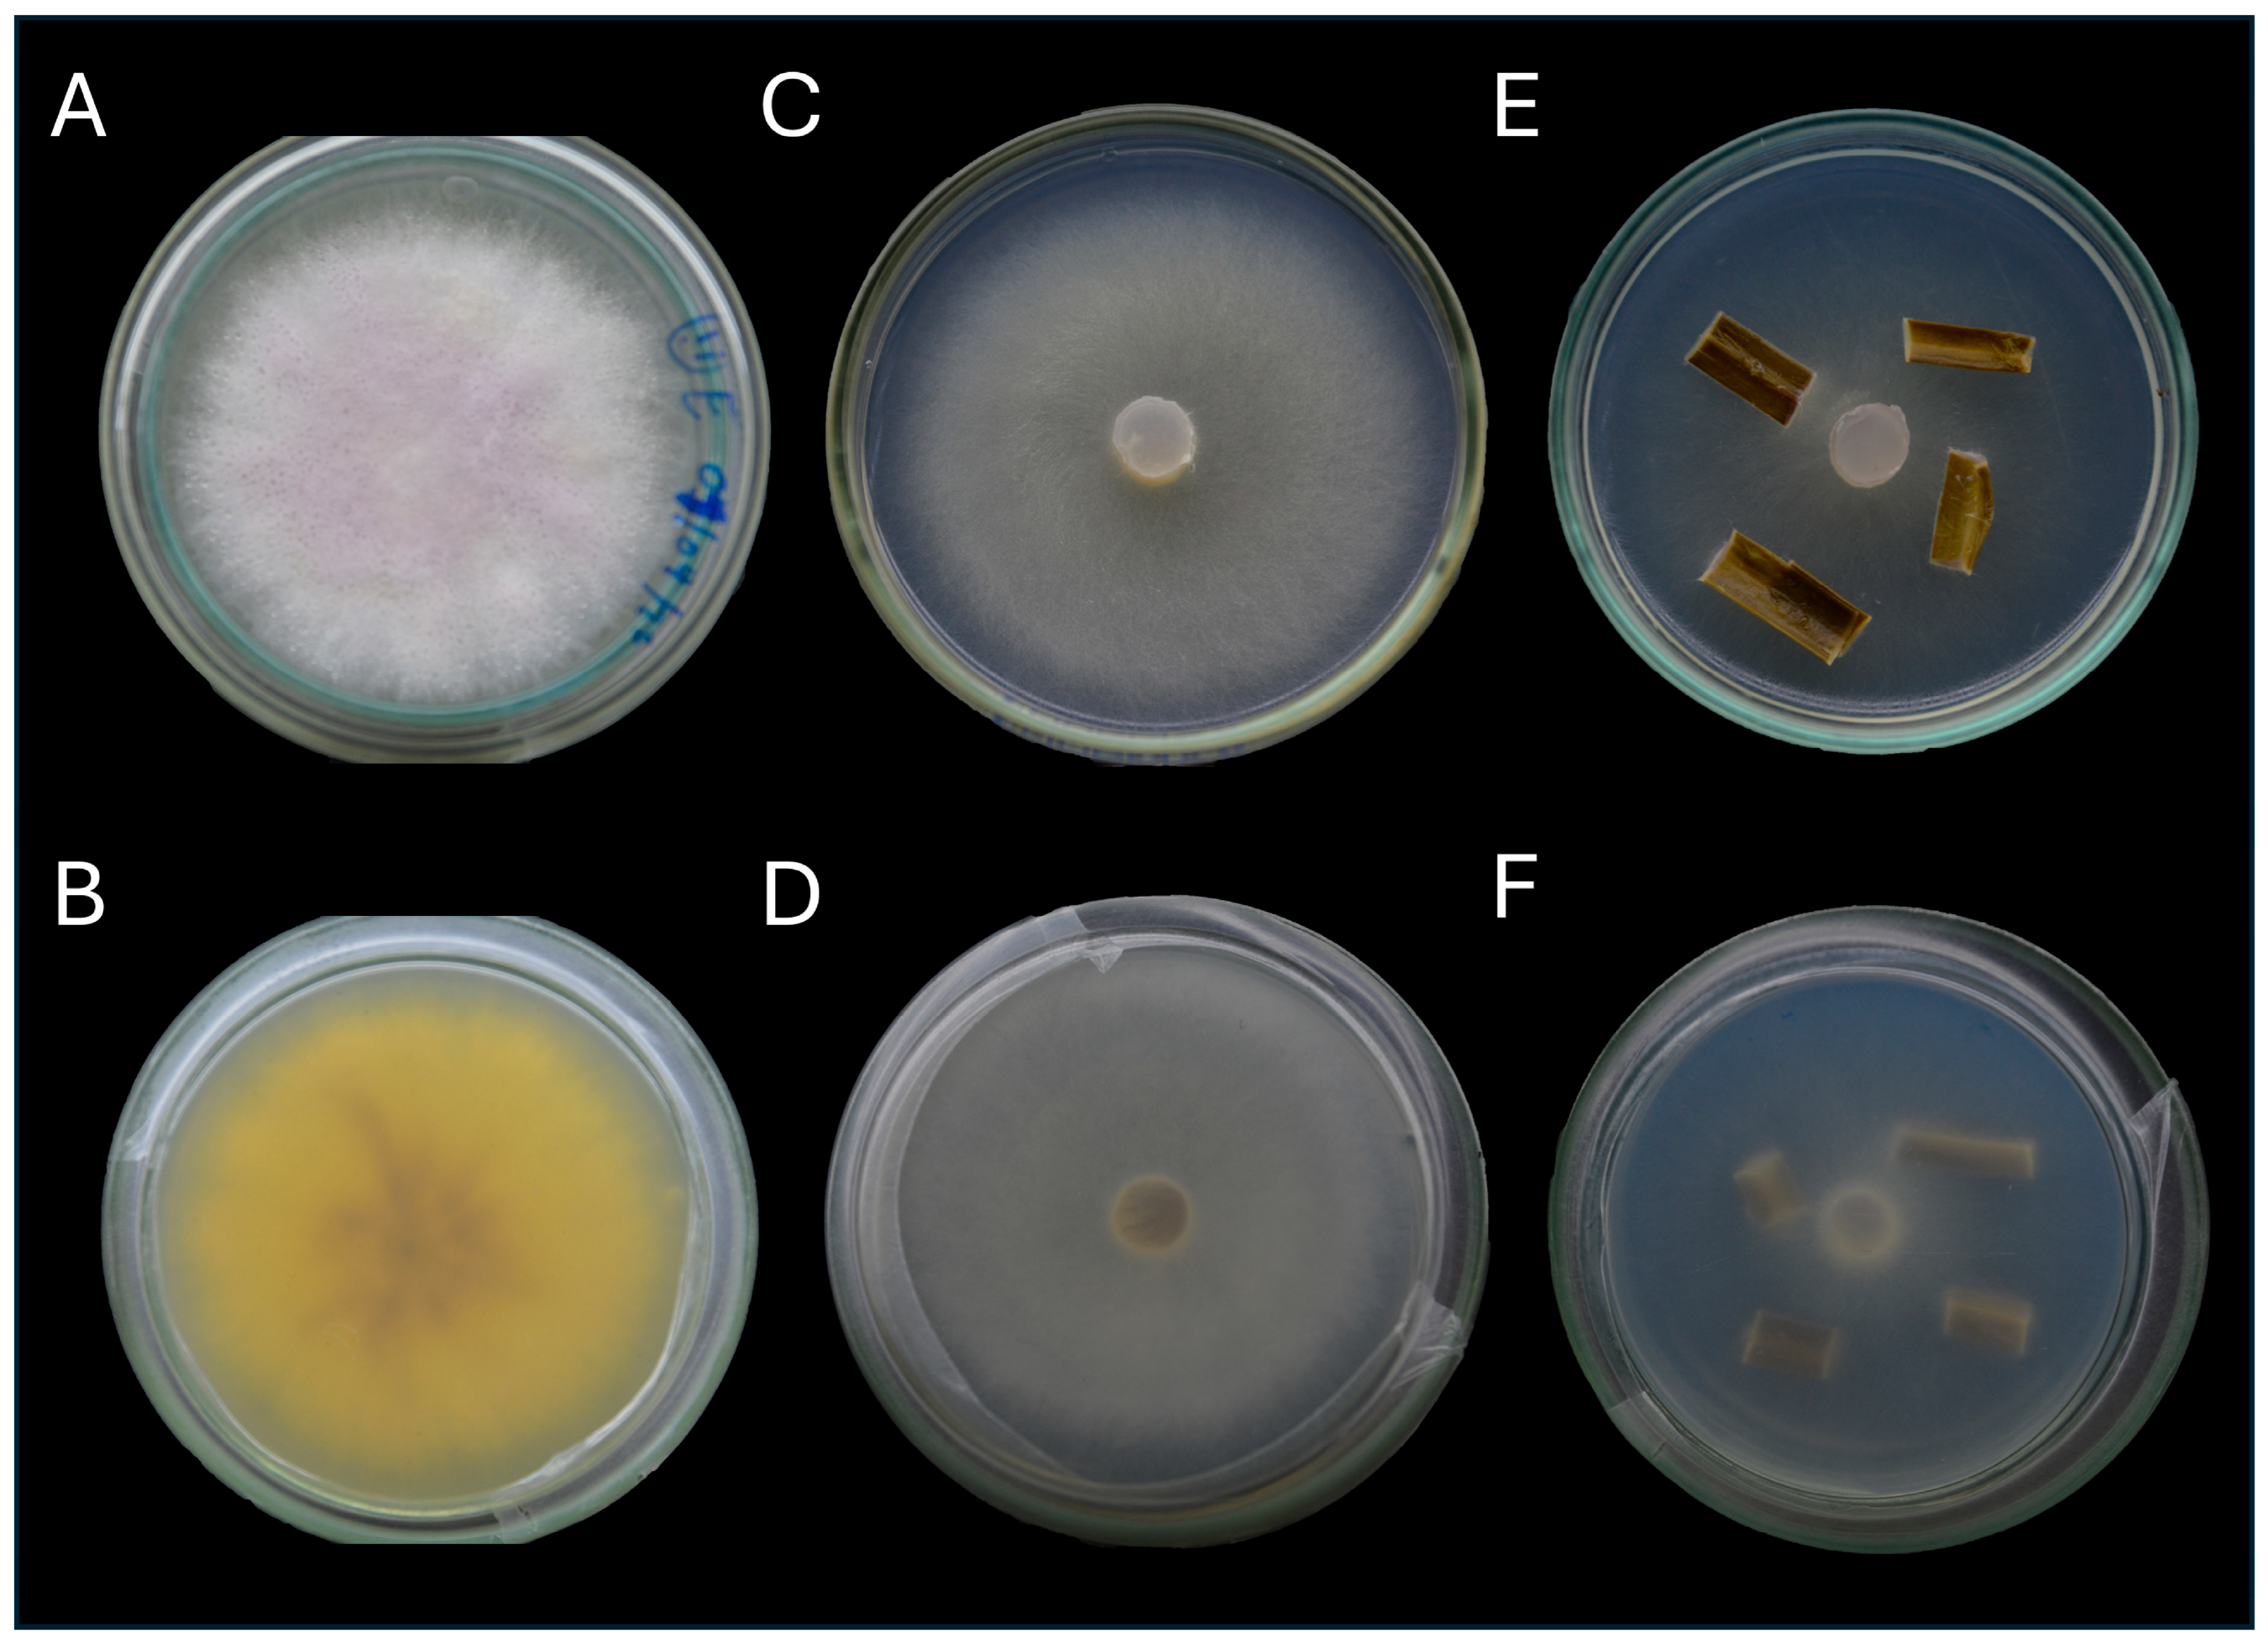
Jof 11 00642 g002

Fusarium suttonianum Identified as the Causal Agent of Root Rot in Plukenetia volubilis in Peru
Abstract
1. Introduction
2. Materials and Methods
2.1. Collection of Biological Samples
2.2. Isolation and Purification of the Pathogen
2.3. Morphological Characterization
2.4. Molecular Characterization
2.5. Phylogenetic Analysis
2.6. Pathogenicity Assays
3. Results
3.1. Morphological Characterization
3.2. Molecular Characterization and Phylogenetic Analysis
3.3. Pathogenicity Assays
4. Discussion
5. Conclusions
Author Contributions
Funding
Institutional Review Board Statement
Informed Consent Statement
Data Availability Statement
Acknowledgments
Conflicts of Interest
References
- Chirinos, R.; Zuloeta, G.; Pedreschi, R.; Mignolet, E.; Larondelle, Y.; Campos, D. Sacha Inchi (Plukenetia volubilis): A Seed Source of Polyunsaturated Fatty Acids, Tocopherols, Phytosterols, Phenolic Compounds and Antioxidant Capacity. Food Chem. 2013, 141, 1732–1739. [Google Scholar] [CrossRef]
- Kodahl, N.; Sørensen, M. Sacha Inchi (Plukenetia volubilis L.) Is an Underutilized Crop with a Great Potential. Agronomy 2021, 11, 1066. [Google Scholar] [CrossRef]
- Supriyanto, S.; Imran, Z.; Ardiansyah, R.; Auliyai, B.; Pratama, A.; Kadha, F. The Effect of Cultivation Conditions on Sacha Inchi (Plukenetia volubilis L.) Seed Production and Oil Quality (Omega 3, 6, 9). Agronomy 2022, 12, 636. [Google Scholar] [CrossRef]
- Abd Rahman, I.Z.; Nor Hisam, N.S.; Aminuddin, A.; Hamid, A.A.; Kumar, J.; Ugusman, A. Evaluating the Potential of Plukenetia volubilis Linneo (Sacha Inchi) in Alleviating Cardiovascular Disease Risk Factors: A Mini Review. Pharmaceuticals 2023, 16, 1588. [Google Scholar] [CrossRef] [PubMed]
- del-Castillo, Á.M.R.; Gonzalez-Aspajo, G.; Sánchez-Márquez, M.d.F.; Kodahl, N. Ethnobotanical Knowledge in the Peruvian Amazon of the Neglected and Underutilized Crop Sacha Inchi (Plukenetia volubilis L.). Econ. Bot. 2019, 73, 281–287. [Google Scholar] [CrossRef]
- Kodahl, N. Sacha Inchi (Plukenetia volubilis L.)—From Lost Crop of the Incas to Part of the Solution to Global Challenges? Planta 2020, 251, 80. [Google Scholar] [CrossRef]
- Cárdenas Sierra, D.M.; Gómez Rave, L.J.; Soto, J.A. Biological Activity of Sacha Inchi (Plukenetia volubilis Linneo) and Potential Uses in Human Health: A Review. Food Technol. Biotechnol. 2021, 59, 253–266. [Google Scholar] [CrossRef]
- Kittibunchakul, S.; Kemsawasd, V.; Hudthagosol, C.; Sanporkha, P.; Sapwarobol, S.; Suttisansanee, U. The Effects of Different Roasting Methods on the Phenolic Contents, Antioxidant Potential, and In Vitro Inhibitory Activities of Sacha Inchi Seeds. Foods 2023, 12, 4178. [Google Scholar] [CrossRef]
- Wang, S.; Zhu, F.; Kakuda, Y. Sacha Inchi (Plukenetia volubilis L.): Nutritional Composition, Biological Activity, and Uses. Food Chem. 2018, 265, 316–328. [Google Scholar] [CrossRef]
- Štěrbová, L.; Hlásná Čepková, P.; Viehmannová, I.; Huansi, D.C. Effect of Thermal Processing on Phenolic Content, Tocopherols and Antioxidant Activity of Sacha Inchi Kernels: Effect of Thermal Processing in Sacha Inchi Kernels. J. Food Process. Preserv. 2017, 41, e12848. [Google Scholar] [CrossRef]
- Goyal, A.; Tanwar, B.; Kumar Sihag, M.; Sharma, V. Sacha Inchi (Plukenetia volubilis L.): An Emerging Source of Nutrients, Omega-3 Fatty Acid and Phytochemicals. Food Chem. 2022, 373, 131459. [Google Scholar] [CrossRef]
- Mai, H.C.; Nguyen, D.C.; Thuong Nhan, N.P.; Bach, L.G. Physico-Chemical Properties of Sacha Inchi (Plukenetia volubilis L.) Seed Oil from Vietnam. Asian J. Chem. 2020, 32, 335–338. [Google Scholar] [CrossRef]
- Mhd Rodzi, N.A.R.; Lee, L.K. Sacha Inchi (Plukenetia volubilis L.): Recent Insight on Phytochemistry, Pharmacology, Organoleptic, Safety and Toxicity Perspectives. Heliyon 2022, 8, e10572. [Google Scholar] [CrossRef]
- Manco, E. Cultivo de Sacha Inchi; Instituto Nacional de Innovación Agraria: La Molina, Peru, 2006. [Google Scholar]
- Manco, E. Sacha Inchi (Plukenetia volubilis L.) Cultivo Promisorio Para la Amazonía Peruana; Instituto Nacional de Innovación Agraria: La Molina, Peru, 2008. [Google Scholar]
- Huaman-Pilco, A.F.; Arce-Inga, M.; Huaman-Pilco, J.; Aguilar-Rafael, V.; Oliva-Cruz, S.M.; Hernández-Díaz, E.; Fernández-Rodríguez, Y.; Torres-Cruz, T.J.; Díaz-Valderrama, J.R. First Report of Basal Rot of Yellow Dragon Fruit (Selenicereus megalanthus) Caused by Fusarium oxysporum in Peru. Plant Dis. 2024, 108, 3189. [Google Scholar] [CrossRef]
- Quispe-Mamani, R.A.; Sulca-Quispe, L.; Huanca-Mamani, W.; Garcia-Castillo, M.G.; Muñoz-Torres, P.; Sepúlveda-Chavera, G. Identification of Fungi Causing Root Rot in Oregano Crops in Southern Peru: Morphological and Molecular Analysis. Pathogens 2025, 14, 746. [Google Scholar] [CrossRef]
- Acuña, R.; Rouard, M.; Leiva, A.M.; Marques, C.; Olortegui, J.A.; Ureta, C.; Cabrera-Pintado, R.M.; Rojas, J.C.; Lopez-Alvarez, D.; Cenci, A.; et al. First Report of Fusarium oxysporum f. Sp. Cubense Tropical Race 4 Causing Fusarium Wilt in Cavendish Bananas in Peru. Plant Dis. 2022, 106, 2268. [Google Scholar] [CrossRef]
- Ministerio de Desarrollo Agrario y Riego. Perfil Productivo de Sacha Inchi En San Martín. Available online: https://siea.midagri.gob.pe/portal/siea_bi/index.html (accessed on 11 November 2024).
- Corazon-Guivin, M.A.; Rengifo-Del Aguila, S.; Hernández-Amasifuen, A.D.; Arévalo-Rojas, V.M.; Acosta-Córdova, R.A.; Cerna-Mendoza, A.; De Araújo Mastrangelo, T.; Valverde-Iparraguirre, J.D.; Guerrero-Abad, J.C. Gamma Irradiation of Plukenetia volubilis L. Seeds Promotes Several Changes During Its Germination and Vegetative Growth. Adv. Agric. 2023, 2023, 9737125. [Google Scholar] [CrossRef]
- Corazon-Guivin, M.A.; Rengifo Del Aguila, S.; Corrêa, R.X.; Cordova-Sinarahua, D.; Costa Maia, L.; Alves Da Silva, D.K.; Alves Da Silva, G.; López-García, Á.; Coyne, D.; Oehl, F. Native Arbuscular Mycorrhizal Fungi Promote Plukenetia volubilis Growth and Decrease the Infection Levels of Meloidogyne Incognita. J. Fungi 2024, 10, 451. [Google Scholar] [CrossRef]
- Wang, G.F.; Li, H.; Zhou, Y.; Yang, L.Y.; Ding, Z.J.; Huang, J.S.; Pan, B.Z. Bacterial Wilt of Sacha Inchi (Plukenetia volubilis) Caused by Ralstonia pseudosolanacearum Phylotype I in Southern China. Plant Dis. 2019, 103, 364. [Google Scholar] [CrossRef]
- Wang, W.; Liu, Z.; Wang, W.; Song, X. First Report of Macrophomina phaseolina Causing Stalk Rot of Sacha Inchi (Plukenetia volubilis) in China. Plant Dis. 2020, 104, 570. [Google Scholar] [CrossRef]
- Wang, W.; Zhang, J.; Li, J. First Report of Colletotrichum siamense Causing Stem Tip Dieback of Sacha Inchi (Plukenetia volubilis) in China. Plant Dis. 2020, 104, 2726. [Google Scholar] [CrossRef]
- Wang, W.; Song, X. First Report of Lasiodiplodia theobromae and L. Pseudotheobromae Causing Canker Disease of Sacha Inchi (Plukenetia volubilis) in Hainan, China. Plant Dis. 2021, 105, 3757. [Google Scholar] [CrossRef]
- Chai, X.; Yang, Z.; Fu, Q.; Pan, B.-Z.; Tang, M.; Li, C.; Xu, Z.-F. First Report of Root and Basal Stem Rot in Sacha Inchi (Plukenetia volubilis) Caused by Fusarium oxysporum in China. Plant Dis. 2018, 102, 242. [Google Scholar] [CrossRef]
- Yang, L.Y.; Chen, P.; Guo, L.J.; Zhou, Y.; Wang, G.F.; Du, Q.J.; Huang, J.S. First Report of Vine Wilt Disease Caused by Fusarium solani on Sacha Inchi (Plukenetia volubilis) in China. Plant Dis. 2017, 101, 1675. [Google Scholar] [CrossRef]
- Uwaremwe, C.; Bao, W.; Daoura, B.G.; Mishra, S.; Zhang, X.; Shen, L.; Xia, S.; Yang, X. Shift in the Rhizosphere Soil Fungal Community Associated with Root Rot Infection of Plukenetia volubilis Linneo Caused by Fusarium and Rhizopus Species. Int. Microbiol. 2023, 27, 1231–1247. [Google Scholar] [CrossRef]
- Guerrero-Abad, J.C.; Padilla-Domínguez, A.; Torres-Flores, E.; López-Rodríguez, C.; Guerrero-Abad, R.; Coyne, D.; Oehl, F.; Corazon-Guivin, M.A. A Pathogen Complex Between the Root Knot Nematode Meloidogyne Incognita and Fusarium verticillioides Results in Extreme Mortality of the Inka Nut (Plukenetia volubilis). J. Appl. Bot. Food Qual. 2021, 94, 162–168. [Google Scholar] [CrossRef]
- Zheng, J.; Wang, L.; Hou, W.; Han, Y. Fusarium oxysporum Associated with Fusarium Wilt on Pennisetum Sinese in China. Pathogens 2022, 11, 999. [Google Scholar] [CrossRef]
- Ekwomadu, T.I.; Mwanza, M. Fusarium Fungi Pathogens, Identification, Adverse Effects, Disease Management, and Global Food Security: A Review of the Latest Research. Agriculture 2023, 13, 1810. [Google Scholar] [CrossRef]
- Ejaz, M.R.; Jaoua, S.; Ahmadi, M.; Shabani, F. An Examination of How Climate Change Could Affect the Future Spread of Fusarium Spp. around the World, Using Correlative Models to Model the Changes. Environ. Technol. Innov. 2023, 31, 103177. [Google Scholar] [CrossRef]
- Nikitin, D.A.; Ivanova, E.A.; Semenov, M.V.; Zhelezova, A.D.; Ksenofontova, N.A.; Tkhakakhova, A.K.; Kholodov, V.A. Diversity, Ecological Characteristics and Identification of Some Problematic Phytopathogenic Fusarium in Soil: A Review. Diversity 2023, 15, 49. [Google Scholar] [CrossRef]
- Xu, X.; Dai, T.; Wu, C. First Report of Fusarium vanettenii Causing Fusarium Root Rot in Fatsia japonica in China. Forests 2024, 15, 805. [Google Scholar] [CrossRef]
- De Figueiredo Silva, F.; Kaplan, S.; Tobar, F.A.M.; Potts, M.D.; Martinez, R.L.E.; Zilberman, D. Estimating Worldwide Benefits from Improved Bananas Resistant to Fusarium Wilt Tropical Race 4. J. Agric. Appl. Econ. Assoc. 2023, 2, 20–34. [Google Scholar] [CrossRef]
- Tiwari, R.K.; Lal, M.K.; Kumar, R.; Sharma, S.; Sagar, V.; Kumar, A.; Singh, B.; Aggarwal, R. Impact of Fusarium Infection on Potato Quality, Starch Digestibility, In Vitro Glycemic Response, and Resistant Starch Content. J. Fungi 2023, 9, 466. [Google Scholar] [CrossRef]
- Abdel-Azeem, A.M.; Abdel-Azeem, M.A.; Darwish, A.G.; Nafady, N.A.; Ibrahim, N.A. Fusarium: Biodiversity, Ecological Significances, and Industrial Applications. In Fungal Biology; Springer International Publishing: Cham, Switzerland, 2019; pp. 201–261. ISBN 978-3-030-10479-5. [Google Scholar]
- Leslie, J.F.; Summerell, B.A. Fusarium Laboratory Workshops—A Recent History. Mycotoxin Res. 2006, 22, 73–74. [Google Scholar] [CrossRef]
- Summerell, B.A. Resolving Fusarium: Current Status of the Genus. Annu. Rev. Phytopathol. 2019, 57, 323–339. [Google Scholar] [CrossRef]
- Yang, X.; Xu, X.; Wang, S.; Zhang, L.; Shen, G.; Teng, H.; Yang, C.; Song, C.; Xiang, W.; Wang, X.; et al. Identification, Pathogenicity, and Genetic Diversity of Fusarium Spp. Associated with Maize Sheath Rot in Heilongjiang Province, China. Int. J. Mol. Sci. 2022, 23, 10821. [Google Scholar] [CrossRef]
- Samiksha; Kumar, S. Molecular Taxonomy, Diversity, and Potential Applications of Genus Fusarium. In Fungal Biology; Springer International Publishing: Cham, Switzerland, 2021; pp. 277–293. ISBN 978-3-030-67560-8. [Google Scholar]
- Antonissen, G.; Martel, A.; Pasmans, F.; Ducatelle, R.; Verbrugghe, E.; Vandenbroucke, V.; Li, S.; Haesebrouck, F.; Van Immerseel, F.; Croubels, S. The Impact of Fusarium Mycotoxins on Human and Animal Host Susceptibility to Infectious Diseases. Toxins 2014, 6, 430–452. [Google Scholar] [CrossRef]
- Olszak-Przybyś, H.; Korbecka-Glinka, G.; Patkowska, E. Identification and Pathogenicity of Fusarium Isolated from Soybean in Poland. Pathogens 2023, 12, 1162. [Google Scholar] [CrossRef]
- Paziani, M.H.; Tonani Carvalho, L.; Melhem, M.D.S.C.; Almeida, M.T.G.D.; da Silva, M.E.N.B.; Martinez, R.; Santos, C.; Kress, M.R.v.Z. First Comprehensive Report of Clinical Fusarium Strains Isolated in the State of Sao Paulo (Brazil) and Identified by MALDI-TOF MS and Molecular Biology. Microorganisms 2019, 8, 66. [Google Scholar] [CrossRef]
- Ismail, M.A.; Abdel-Hafez, S.I.I.; Hussein, N.A.; Abdel-Hameed, N.A. Contribution to Physiological and Biochemical Diagnostics of Fusarium Taxa Commonly Isolated in Egypt. Czech Mycol. 2013, 65, 133–150. [Google Scholar] [CrossRef]
- Hami, A.; Rasool, R.S.; Khan, N.A.; Mansoor, S.; Mir, M.A.; Ahmed, N.; Masoodi, K.Z. Morpho-Molecular Identification and First Report of Fusarium equiseti in Causing Chilli Wilt from Kashmir (Northern Himalayas). Sci. Rep. 2021, 11, 3610. [Google Scholar] [CrossRef]
- Ma, T.; Yang, C.; Cai, F.; Osei, R. Molecular Identification and Characterization of Fusarium Associated with Walnut Branch Blight Disease in China. Pathogens 2023, 12, 970. [Google Scholar] [CrossRef]
- Zhang, Y.; Chen, C.; Zhao, J.; Chen, C.; Lin, J.; Jayawardena, R.S.; Xiang, M.; Manawasinghe, I.S.; You, C. Fusarium Elaeidis Causes Stem and Root Rot on Alocasia longiloba in South China. Pathogens 2021, 10, 1395. [Google Scholar] [CrossRef]
- Milošević, D.; Ignjatov, M.; Nikolić, Z.; Tamindžić, G.; Miljaković, D.; Marinković, J.; Červenski, J. Molecular Characterization of Fusarium proliferatum and F. Equiseti of Pisum sativum Seed. Legume Res. 2022, 46, 233–237. [Google Scholar] [CrossRef]
- Wang, L.; Wang, N.; Yu, J.; Wu, J.; Liu, H.; Lin, K.; Zhang, Y. Identification of Pathogens Causing Alfalfa Fusarium Root Rot in Inner Mongolia, China. Agronomy 2023, 13, 456. [Google Scholar] [CrossRef]
- Engalycheva, I.; Kozar, E.; Frolova, S.; Vetrova, S.; Tikhonova, T.; Dzhos, E.; Engalychev, M.; Chizhik, V.; Martynov, V.; Shingaliev, A.; et al. Fusarium Species Causing Pepper Wilt in Russia: Molecular Identification and Pathogenicity. Microorganisms 2024, 12, 343. [Google Scholar] [CrossRef]
- Diabankana, R.G.C.; Frolov, M.; Islamov, B.; Shulga, E.; Filimonova, M.N.; Afordoanyi, D.M.; Validov, S. Identification and Aggressiveness of Fusarium Species Associated with Onion Bulb (Allium cepa L.) During Storage. J. Fungi 2024, 10, 161. [Google Scholar] [CrossRef]
- Bibi, A.; Mubeen, F.; Rizwan, A.; Ullah, I.; Hammad, M.; Waqas, M.A.B.; Ikram, A.; Abbas, Z.; Halterman, D.; Saeed, N.A. Morpho-Molecular Identification of Fusarium equiseti and Fusarium oxysporum Associated with Symptomatic Wilting of Potato from Pakistan. J. Fungi 2024, 10, 701. [Google Scholar] [CrossRef]
- Balasubramaniam, J.; Goh, K.S.; Sani, S.F.; Alam, M.W.; Ismail, N.A.; Gleason, M.L.; Rosli, H. Fusarium falciforme and F. oxysporum Causing Postharvest Fruit Rot of Watermelon (Citrullus lanatus) in Malaysia: A First Report. Crop Prot. 2023, 163, 106115. [Google Scholar] [CrossRef]
- Kim, S.G.; Ko, H.-C.; Hur, O.-S.; Luitel, B.P.; Rhee, J.-H.; Yoon, M.-S.; Baek, H.-J.; Ryu, K.-Y.; Sung, J.S. First Report of Fusarium Wilt Caused by Fusarium proliferatum on Safflower. Res. Plant Dis. 2016, 22, 111–115. [Google Scholar] [CrossRef]
- Vega-Gutiérrez, T.A.; López-Urquídez, G.A.; Allende-Molar, R.; Amarillas-Bueno, L.A.; Romero-Gómez, S.D.J.; López-Orona, C.A. Aggressiveness and Molecular Characterization of Fusarium Spp. Associated with Foot Rot and Wilt in Tomato in Sinaloa, Mexico. 3 Biotech 2019, 9, 276. [Google Scholar] [CrossRef] [PubMed]
- Duvnjak, T.; Vrandecic, K.; Sudaric, A.; Cosic, J.; Siber, T.; Matosa Kocar, M. First Report of Hemp Fusarium Wilt Caused by Fusarium oxysporum in Croatia. Plants 2023, 12, 3305. [Google Scholar] [CrossRef]
- Bugingo, C.; Infantino, A.; Okello, P.; Perez-Hernandez, O.; Petrović, K.; Turatsinze, A.N.; Moparthi, S. From Morphology to Multi-Omics: A New Age of Fusarium Research. Pathogens 2025, 14, 762. [Google Scholar] [CrossRef] [PubMed]
- Geiser, D.M.; Al-Hatmi, A.M.S.; Aoki, T.; Arie, T.; Balmas, V.; Barnes, I.; Bergstrom, G.C.; Bhattacharyya, M.K.; Blomquist, C.L.; Bowden, R.L.; et al. Phylogenomic Analysis of a 55.1-Kb 19-Gene Dataset Resolves a Monophyletic Fusarium That Includes the Fusarium solani Species Complex. Phytopathology 2021, 111, 1064–1079. [Google Scholar] [CrossRef]
- Werres, S. (Ed.) PROTOCOL 01-09.1: Preparation of Hyphal Tip Phytophthora Cultures. In Laboratory Protocols for Phytophthora Species; The American Phytopathological Society: St. Paul, MN, USA, 2015; pp. 1–2. ISBN 978-0-89054-496-9. [Google Scholar]
- Thomas, V.E.; Antony-Babu, S. Core Hyphosphere Microbiota of Fusarium oxysporum f. Sp. Niveum. Environ. Microbiome 2024, 19, 14. [Google Scholar] [CrossRef]
- Summerell, B.A.; Salleh, B.; Leslie, J.F. A Utilitarian Approach to Fusarium Identification. Plant Dis. 2003, 87, 117–128. [Google Scholar] [CrossRef]
- Kamali-Sarvestani, S.; Mostowfizadeh-Ghalamfarsa, R.; Salmaninezhad, F.; Cacciola, S.O. Fusarium and Neocosmospora Species Associated with Rot of Cactaceae and Other Succulent Plants. J. Fungi 2022, 8, 364. [Google Scholar] [CrossRef] [PubMed]
- Silva, S.G.A.; Costa, M.M.; Cardoso, A.M.S.; Nascimento, L.V.; Barroso, K.A.; Nunes, G.H.S.; Pfenning, L.H.; Ambrósio, M.M.Q. Fusarium falciforme and Fusarium suttonianum Cause Root Rot of Melon in Brazil. Plant Pathol. 2023, 72, 721–730. [Google Scholar] [CrossRef]
- White, T.J.; Bruns, T.; Lee, S.; Taylor, J. Amplification and Direct Sequencing of Fungal Ribosomal RNA Genes for Phylogenetics. In PCR Protocols; Elsevier: Amsterdam, The Netherlands, 1990; pp. 315–322. ISBN 978-0-12-372180-8. [Google Scholar]
- O’Donnell, K.; Kistler, H.C.; Cigelnik, E.; Ploetz, R.C. Multiple Evolutionary Origins of the Fungus Causing Panama Disease of Banana: Concordant Evidence from Nuclear and Mitochondrial Gene Genealogies. Proc. Natl. Acad. Sci. USA 1998, 95, 2044–2049. [Google Scholar] [CrossRef]
- Katoh, K.; Rozewicki, J.; Yamada, K.D. MAFFT Online Service: Multiple Sequence Alignment, Interactive Sequence Choice and Visualization. Brief. Bioinform. 2019, 20, 1160–1166. [Google Scholar] [CrossRef]
- Milne, I.; Lindner, D.; Bayer, M.; Husmeier, D.; McGuire, G.; Marshall, D.F.; Wright, F. TOPALi v2: A Rich Graphical Interface for Evolutionary Analyses of Multiple Alignments on HPC Clusters and Multi-Core Desktops. Bioinformatics 2009, 25, 126–127. [Google Scholar] [CrossRef]
- Ronquist, F.; Huelsenbeck, J.P. MrBayes 3: Bayesian Phylogenetic Inference under Mixed Models. Bioinformatics 2003, 19, 1572–1574. [Google Scholar] [CrossRef]
- Guindon, S.; Gascuel, O. A Simple, Fast, and Accurate Algorithm to Estimate Large Phylogenies by Maximum Likelihood. Syst. Biol. 2003, 52, 696–704. [Google Scholar] [CrossRef]
- Cachique, D.H.; Solsol, H.R.; Sanchez, M.A.G.; López, L.A.A.; Kodahl, N. Vegetative Propagation of the Underutilized Oilseed Crop Sacha Inchi (Plukenetia volubilis L.). Genet. Resour. Crop Evol. 2018, 65, 2027–2036. [Google Scholar] [CrossRef]
- Wang, Y.; Xie, Y.; Cui, H.D.; Dong, Y. First Report of Meloidogyne javanica on Sacha Inchi (Plukenetia volubilis) in China. Plant Dis. 2014, 98, 165. [Google Scholar] [CrossRef]
- Van, Q.; Pham Thi, N.Y.; Thi, T.; Van, M.; Le Van, T.; Vu Thi, B.N.; Nguyen Thi, B.H. Variation in Growth and Yield of Sacha Inchi (Plukenetia volubilis L.) Under Different Ecological Regions in Vietnam. J. Ecol. Eng. 2022, 23, 161–168. [Google Scholar] [CrossRef]
- Istiandari, P.; Faizal, A. Integrating In Vitro Cultivation and Sustainable Field Practices of Sacha Inchi (Plukenetia volubilis L.) for Enhanced Oil Yield and Quality: A Review. Horticulturae 2025, 11, 194. [Google Scholar] [CrossRef]
- O’Donnell, K.; Whitaker, B.K.; Laraba, I.; Proctor, R.H.; Brown, D.W.; Broders, K.; Kim, H.-S.; McCormick, S.P.; Busman, M.; Aoki, T.; et al. DNA Sequence-Based Identification of Fusarium: A Work in Progress. Plant Dis. 2022, 106, 1597–1609. [Google Scholar] [CrossRef] [PubMed]
- Sandoval-Denis, M.; Crous, P.W. Removing Chaos from Confusion: Assigning Names to Common Human and Animal Pathogens in Neocosmospora. Persoonia 2018, 41, 109–129. [Google Scholar] [CrossRef]
- James, J.E.; Santhanam, J.; Zakaria, L.; Mamat Rusli, N.; Abu Bakar, M.; Suetrong, S.; Sakayaroj, J.; Abdul Razak, M.F.; Lamping, E.; Cannon, R.D. Morphology, Phenotype, and Molecular Identification of Clinical and Environmental Fusarium solani Species Complex Isolates from Malaysia. J. Fungi 2022, 8, 845. [Google Scholar] [CrossRef] [PubMed]
- Aguilar-Anccota, R.; Arévalo-Quinde, C.G.; Morales-Pizarro, A.; Galecio-Julca, M. Fungi Associated with Necrosis of Vascular Bundles in Organic Banana Crop: Symptoms, Isolation and Identification, and Integrated Management Alternatives. Sci. Agropecu. 2021, 12, 249–256. [Google Scholar] [CrossRef]
- Booth, C. The Genus Fusarium; Commonwealth Agricultural Bureaux for the Commonwealth Mycological Institute: Farnham Royal, UK, 1971; ISBN 978-0-85198-046-1. [Google Scholar]
- Ma, Y.-M.; Zhu, J.-Z.; Li, X.-G.; Wang, L.-L.; Zhong, J. Identification and First Report of Fusarium andiyazi Causing Sheath Rot of Zizania Latifolia in China. Plants 2021, 10, 1844. [Google Scholar] [CrossRef] [PubMed]
- Yang, J.; Ahmed, W.; Zhang, J.; Gao, S.; Wang, Z.; Yang, H.; Bai, X.; Luo, K.; Xu, C.; Ji, G. Identification of Fusarium oxysporum Causing Leaf Blight on Dendrobium chrysotoxum in Yunnan Province, China. Life 2024, 14, 285. [Google Scholar] [CrossRef] [PubMed]
- Bickerstaff, J.R.M.; Jordal, B.H.; Riegler, M. Two Sympatric Lineages of Australian Cnestus solidus Share Ambrosiella symbionts but Not Wolbachia. Heredity 2024, 132, 43–53. [Google Scholar] [CrossRef]

| Species | Isolate | GenBank Accession | |
|---|---|---|---|
| ITS | TEF-1α | ||
| F. suttonianum | LBGM-FUSA001 | PQ636870 | PQ639345 |
| F. suttonianum | NRRL:32858 | DQ094617.1 | DQ247163.1 |
| F. suttonianum | NRRL:32316 | DQ094413.1 | DQ246944.1 |
| F. suttonianum | 145FUS | MW390928.1 | MW389356.1 |
| F. suttonianum | CGMHD4138 | LC683311.1 | LC683363.1 |
| F. suttonianum | CGMHD2740 | LC683304.1 | LC683356.1 |
| F. suttonianum | CGMHD2224 | LC683301.1 | LC683353.1 |
| F. suttonianum | CGMHD0633 | LC683273.1 | LC683325.1 |
| F. suttonianum | CGMHD1911 | LC687548.1 | LC697786.1 |
| F. suttonianum | F27 | PP421949.1 | PP480018.1 |
| F. falciforme | FSSC-Bi004P | KF647700.1 | KF647715.1 |
| F. falciforme | HN-01 | PP779839.1 | PP797138.1 |
| F. falciforme | HN-02 | PP779840.1 | PP797139.1 |
| F. falciforme | HN-03 | PP779841.1 | PP797140.1 |
| F. falciforme | HN-04 | PP779842.1 | PP797141.1 |
| F. falciforme | FSSC-N032P | KF647701.1 | KF647716.1 |
| F. falciforme | SP-Ff-Kd | PP851105.1 | PP858878.1 |
| F. falciforme | CBS475.67 | NR_164424.1 | LT906669.1 |
| F. solani | LC13841 | MW016727.1 | MW620188.1 |
| F. solani | LC13845 | MW016731.1 | MW620192.1 |
| F. solani | LC13842 | MW016728.1 | MW620189.1 |
| F. solani | LC13844 | MW016730.1 | |
| F. solani | GJS 09-1466 | KT313633.1 | KT313611.1 |
| F. solani | NRRL:32484 | DQ094449.1 | DQ246982.1 |
| F. solani | NRRL 43474 | EF453097.1 | EF452945.1 |
| F. solani | LC13843 | MW016729 | MW620190 |
| F. keratoplasticum | JMRC: NRZ:0164 | MF467481.1 | MF467460.1 |
| F. keratoplasticum | JMRC: NRZ:0049 | MF467482.1 | MF467459.1 |
| F. keratoplasticum | FRC S-2496 | JN235276.1 | JN235706.1 |
| F. keratoplasticum | NRRL 32959 | DQ094632.1 | DQ247178.1 |
| F. keratoplasticum | FSSCKer2 | KX868663.1 | KX266293.1 |
| F. keratoplasticum | FSSCKer3 | KX868664.1 | KX266294.1 |
| F. oxysporum | S11 | MW019949.1 | MT772142.1 |
| F. incarnatum | LC13705 | MW016532.1 | MW594375.1 |
| F. equiseti | NRRL20697 | GQ505683.1 | GQ505594.1 |
Disclaimer/Publisher’s Note: The statements, opinions and data contained in all publications are solely those of the individual author(s) and contributor(s) and not of MDPI and/or the editor(s). MDPI and/or the editor(s) disclaim responsibility for any injury to people or property resulting from any ideas, methods, instructions or products referred to in the content. |
© 2025 by the authors. Licensee MDPI, Basel, Switzerland. This article is an open access article distributed under the terms and conditions of the Creative Commons Attribution (CC BY) license (https://creativecommons.org/licenses/by/4.0/).
Share and Cite
Delgado-Mera, E.; Hernández-Amasifuen, A.D.; Tuesta-Casique, Á.; Chumacero-Acosta, J.S.; Cosme-Garate, G.A.; Alves da Silva, G.; Carvajal Vallejos, F.M.; Xavier Corrêa, R.; Corazon-Guivin, M.A. Fusarium suttonianum Identified as the Causal Agent of Root Rot in Plukenetia volubilis in Peru. J. Fungi 2025, 11, 642. https://doi.org/10.3390/jof11090642
Delgado-Mera E, Hernández-Amasifuen AD, Tuesta-Casique Á, Chumacero-Acosta JS, Cosme-Garate GA, Alves da Silva G, Carvajal Vallejos FM, Xavier Corrêa R, Corazon-Guivin MA. Fusarium suttonianum Identified as the Causal Agent of Root Rot in Plukenetia volubilis in Peru. Journal of Fungi. 2025; 11(9):642. https://doi.org/10.3390/jof11090642
Chicago/Turabian StyleDelgado-Mera, Elvin, Angel David Hernández-Amasifuen, Ángel Tuesta-Casique, Julio Santiago Chumacero-Acosta, Gerry Antonio Cosme-Garate, Gladstone Alves da Silva, Fernando Marcelo Carvajal Vallejos, Ronan Xavier Corrêa, and Mike Anderson Corazon-Guivin. 2025. "Fusarium suttonianum Identified as the Causal Agent of Root Rot in Plukenetia volubilis in Peru" Journal of Fungi 11, no. 9: 642. https://doi.org/10.3390/jof11090642
APA StyleDelgado-Mera, E., Hernández-Amasifuen, A. D., Tuesta-Casique, Á., Chumacero-Acosta, J. S., Cosme-Garate, G. A., Alves da Silva, G., Carvajal Vallejos, F. M., Xavier Corrêa, R., & Corazon-Guivin, M. A. (2025). Fusarium suttonianum Identified as the Causal Agent of Root Rot in Plukenetia volubilis in Peru. Journal of Fungi, 11(9), 642. https://doi.org/10.3390/jof11090642

